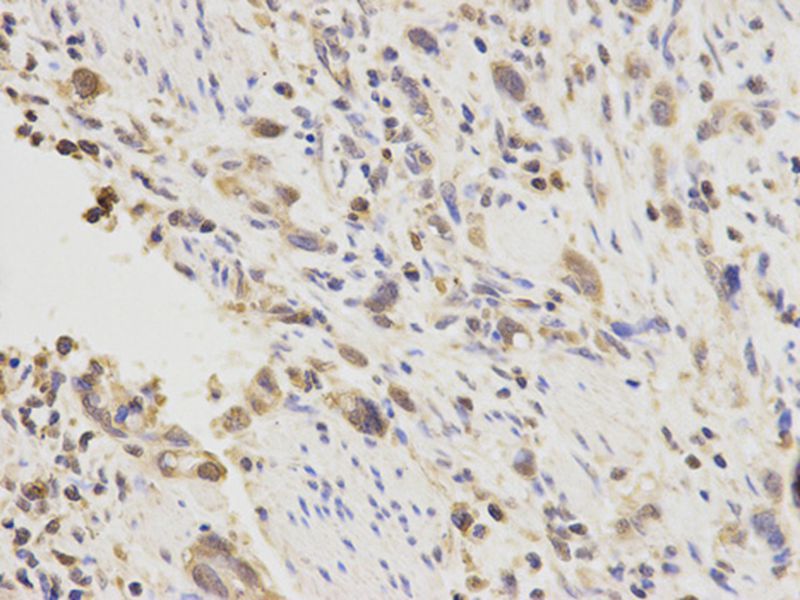
Product Image

Anti-PGF Antibody
A39078
ApplicationsWestern Blot, ImmunoHistoChemistry
Product group Antibodies
ReactivityHuman, Rat
Overview
- SupplierAntibodies.com
- Product NameAnti-PGF Antibody
- Delivery Days Customer7
- ApplicationsWestern Blot, ImmunoHistoChemistry
- CertificationResearch Use Only
- ClonalityPolyclonal
- Concentration1.0 mg/ml
- ConjugateUnconjugated
- HostRabbit
- Scientific DescriptionRabbit polyclonal antibody to PGF
- ReactivityHuman, Rat
- UNSPSC12352203

![Sandwich ELISA detection of recombinant Human PLGF protein, His tag (GTX138450-pro) using antibodies as below. Capture: PLGF antibody [GT57] (GTX641446) (5 μg/mL) Detection: PLGF antibody [HL2682] (GTX639346) (1 μg/mL)](https://www.genetex.com/upload/website/prouct_img/normal/GTX639346/GTX639346_T-45222_20241220_ELISA_PAIR_24123021_606.webp)

